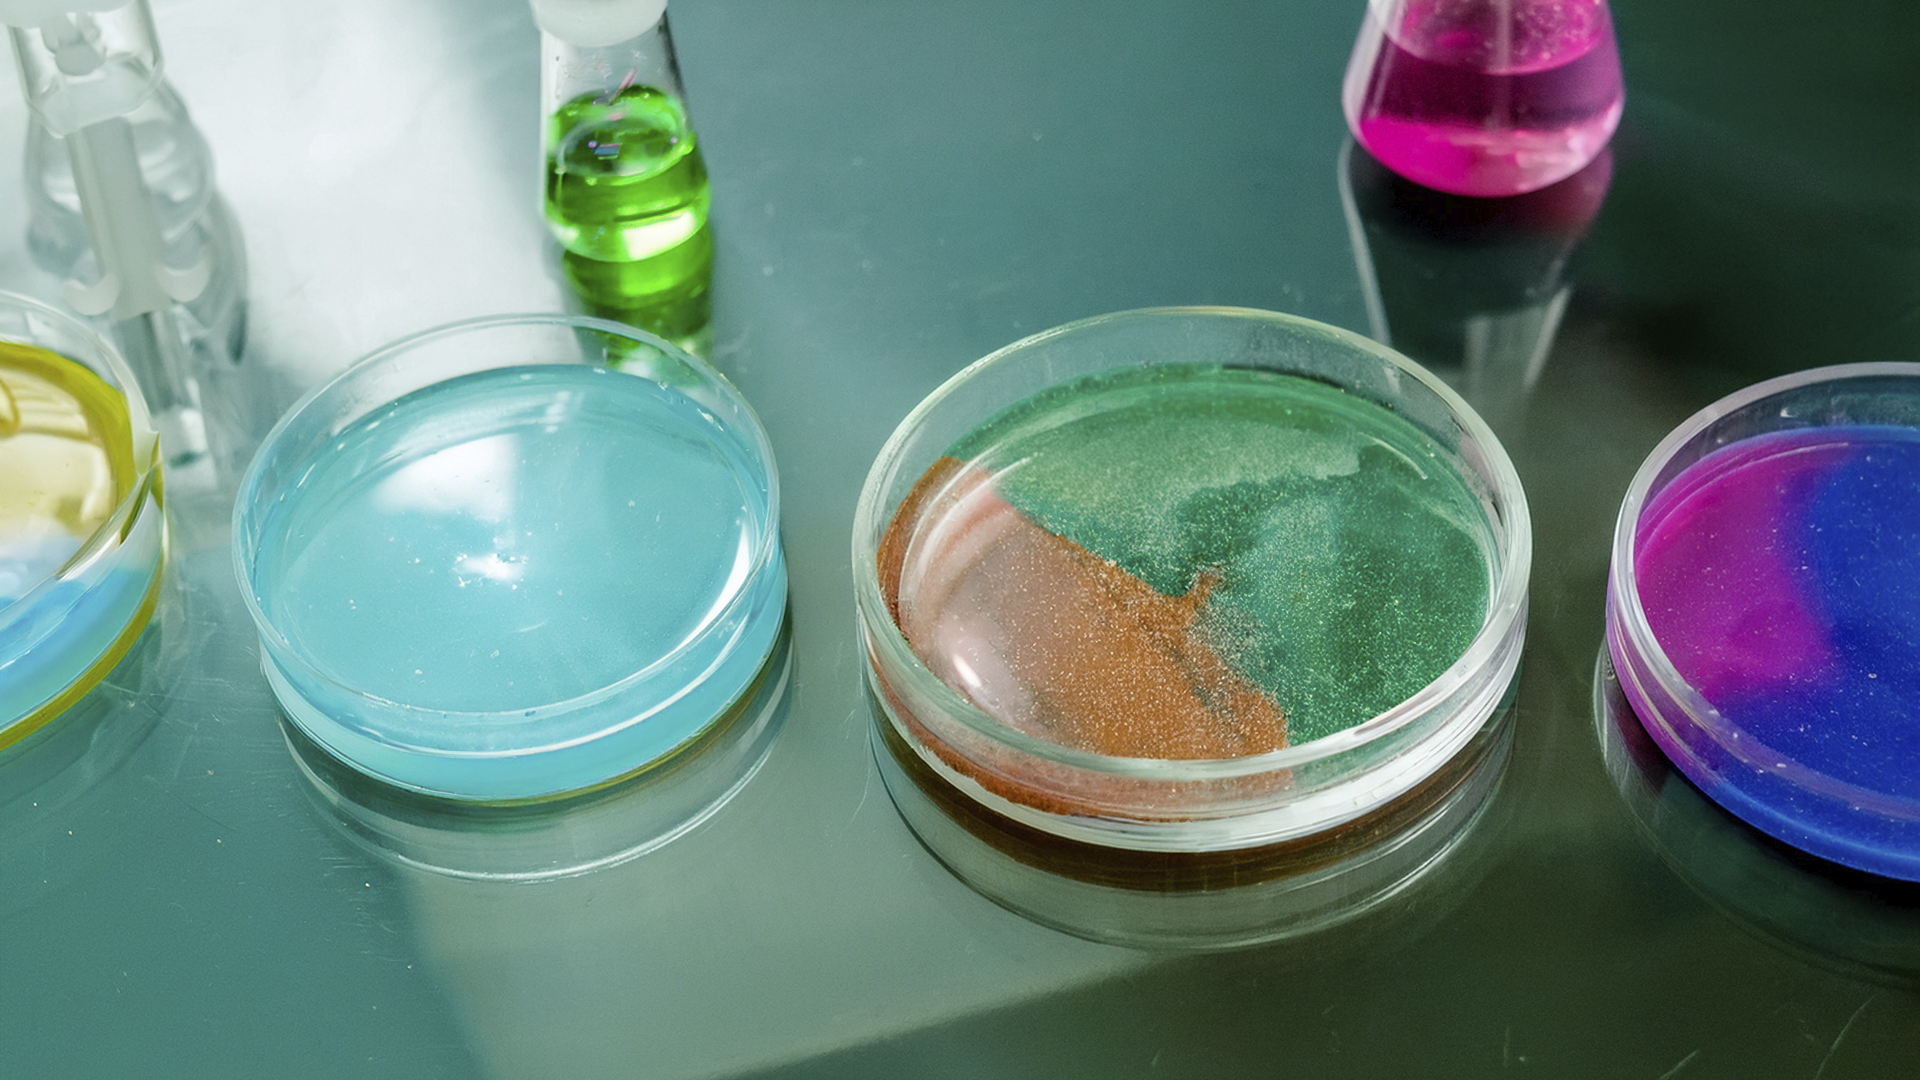

Verdens største land er 397 gange større end Danmark og strækker sig fra Østersøen til Stillehavet.
Lige nu læser andre
Hvilket land er verdens største?
Der er forskel på, om man måler verdens største land ud fra areal eller befolkningstal, men vurderer man kun ud fra størrelsen, så er der ingen tvivl.
Rusland er verdens største land. Nationen mod øst strækker sig hele 17.125.200 kvadratkilometer – hvilket er syv millioner kvadratkilometer større end nummer to på listen.
Til sammenligning er Danmark kun verdens 129. største land – med mindre vi tæller Grønland med. For Kongeriget Danmark – inklusiv Grønland og Færøerne – er faktisk på hele 2.210.583 kvadratkilometer, hvilket gør det til verdens 12. største land.
Læs også
Her kan du se en liste over verdens 10 største lande.
Top 10 – Verdens største land
- Rusland – 17.125.200 kvadratkilometer
- Canada – 9.984.670 kvadratkilometer
- USA – 9.629.091 kvadratkilometer
- Kina – 9.598.093 kvadratkilometer
- Brasilien – 8.514.877 kvadratkilometer
- Australien – 7.692.024 kvadratkilometer
- Indien – 3.287.263 kvadratkilometer
- Argentina – 2.780.400 kvadratkilometer
- Kasakhstan – 2.724.900 kvadratkilometer
- Algeriet – 2.381.741 kvadratkilometer

Verdens største land – fakta
- Rusland: Rusland er verdens største land og dækker mere end en ottendedel af jordens beboede landområde. Samtidig har Rusland den niende største befolkning med over 144 millioner indbyggere. Omkring 77 procent af befolkningen bor i europæisk-Rusland. Rusland er sammen med USA og Kina én af verdens tre supermagter.
- Canada: Canada strækker sig fra Atlanterhavet i øst og til Stillehavet i vest og er arealmæssigt verdens næststørste land. Canada blev beboet for 12.000 år siden, da indianere fra det nuværende USA strømmede nordpå og befolkede landet. Den britiske monark er formelt statsoverhoved i Canada, der har to officielle sprog – engelsk og fransk.
- USA: USA er verdens tredjestørste land og består af 50 stater. Landet er ligeledes det tredje folkerigeste land i verden med en befolkning på mere end 320 millioner. USA er et af de lande i verden med flest etniske grupper, da landet er resultatet af stor immigration fra hele verden igennem flere hundrede år. Landet blev selvstændigt, da man i 1776 opnåede uafhængighed af Storbritannien.
- Kina: Selvom Kina kun er verdens fjerdestørste land, er det verdens mest folkerige med en befolkning på knap 1,4 milliard mennesker, hvilket svarer til cirka en femtedel af jordens befolkning. Kina kan også bryste sig af at være den største eksportør i verden, og landet er styret af Kinas kommunistiske parti med hovedsæde i hovedstaden Beijing.
- Brasilien: Som det femtestørste land i verden er Brasilien også det største portugisisktalende land på kloden samt det største land i Sydamerika. Brasilien dækker i øvrigt 47,3 procent af Sydamerikas samlede areal og grænser op til alle øvrige sydamerikanske lande undtagen Chile og Ecuador. I 1822 opnåede Brasilien uafhængighed fra Portugal.
- Australien: Da Australien er for stor til at være en ø, er landet i stedet et selvstændigt kontinent og verdens sjettestørste land. Hovedstaden er Canberra, mens den største by er Sydney. Australien blev befolket af aboriginerne for omkring 50.000 år siden, men blev koloniseret af briter i slutningen af det 18. århundrede. Landet fik uafhængighed fra Storbritannien i 1901.
- Indien: Indien er det syvende største land i verden og dét land med det næsthøjeste antal indbyggere med 1,3 milliard mennesker. I Indien snakkes der mere end 100 forskellige sprog, men de primære er hindi og engelsk. Det nuværende Indien blev etableret i 1947, da landet blev uafhængig fra Storbritannien samtidig med, at det muslimske Pakistan blev udskilt fra Indien.
- Argentina: Argentina er det ottende største land i verden og det andetstørste land i Latinamerika. Argentina består af 32 provinser, mens hovedstaden er storbyen Buenos Aires. Der har boet mennesker i det nuværende Argentina siden den ældste stenalder, men det blev koloniseret af spanierne i det 16. århundrede. Landet opnåede dog uafhængighed fra Spanien i 1816. I gennem 18- og 1900-taller oplevede Argentina en stor bølger af europæiske immigranter.
- Kasakhstan: Kasakhstan er det niende største land i verden og befinder sig både Europa og Centralasien. På trods af sin størrelse er landet dog tyndt befolket med et indbyggertal på kun 16 millioner. Dermed er befolkningstætheden mindre end seks personer per kvadratkilometer. Landet består da også af store områder med skove, stepper, deltaer, sneklædte bjerge og ørkener.
- Algeriet: Algeriet er det tiendestørste land i verden og det største land i Afrika og blandt Middelhavslandene. Det ligger ud til Middelhavet og har fået sit navn efter hovedstaden Algier. Algeriet var i 132 år en fransk koloni, men opnåede sin uafhængighed i 1962 efter en længere periode med borgerkrig og konflikter. Landet har en befolkning på 37,1 millioner indbyggere.

Måler man verdens største land ud fra befolkningsstørrelser, går kun halvdelen af de førnævnte lande igen.
Top 10 – Verdens folkerigeste land
- Kina – 1,379 milliarder
- Indien – 1,324 milliarder
- USA – 323,1 millioner
- Indonesien – 261,1 millioner
- Brasilien – 207,7 millioner
- Pakistan – 193,2 millioner
- Nigeria – 186 millioner
- Bangladesh – 163 millioner
- Japan – 127 millioner